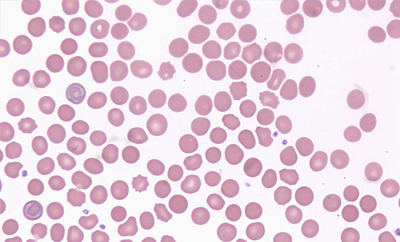
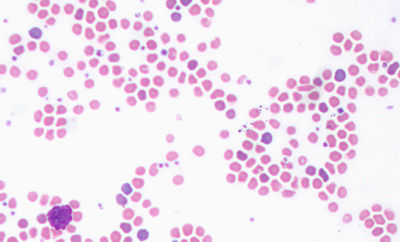

Vision Hema® Vet Решения для каждой ветеринарной лабор
Арт. 2403
Характеристики
Страна происхождения
—
Австрия
Специализированные сканеры-анализаторы
Цена по запросу
Подробнее
Комплектации
Идентификация и преклассификация лейкоцитов
-
Базофилы
-
Эозинофилы
-
Промиелоциты
-
Миелоциты
-
Палочкоядерные нейтрофилы
-
Сегментоядерные нейтрофилы
-
Лимфоциты
-
Моноциты
-
Метамиелоциты
-
Бласты
-
Реактивные лимфоциты
-
Эритробласты
Анализ эритроцитов
-
Размер
-
Цвет
-
Форма
-
Включения
Анализ тромбоцитов
-
Нормальные
-
Микро
-
Макро
Сканирование «метелки мазка»
-
Дополнительная оценка атипичных форм лейкоцитов
-
Оценка агрегации тромбоцитов
Идентификация клеток крови животных
Собаки, кошки, мыши, кролики, козы, обезьяны, слоны и другие
Искусственный интеллект
Искусственный интеллект (ИИ) — вид алгоритмов/технологий, благодаря которым компьютеры способны учиться и решать интеллектуальные задачи, которые перед ними ставит человек. ИИ ускоряет процесс обработки и интерпретации данных, помогая эффективно выполнять сложные задачи, в том числе и такие, как анализ медицинских изображений.
Клетки крови животных
Дополнительные модули
Vision Extended RBC Vet
Идентификация эритроцитов по размеру, цвету, форме и включениям. Пре-классификация эритроцитов по 21 параметру. Детальная информация по каждому эритроциту.
Vision Extended PLT Vet
Идентификация и пре-классификация тромбоцитов по 3-м параметрам: микро, макро, нормальные. Детальная информация по каждому тромбоциту.
Административные модули
Vision Manager
Автоматизация проведения анализа, правила обработки данных.
Vision Remote
Удаленное рабочее место.
Модули для консультации и обучения
Vision Suite
Облачная/серверная платформа для телемедицины и консультации с коллегами.
Vision Expertise
Онлайн-тестирование и контроль качества.
Клиническое применение
Последние разработки в области искусственного интеллекта решают задачи автоматизации цифровой микроскопии. Наши технологии улучшают диагностический процесс, сокращают время анализа, снижают субъективность полученных результатов. Благодаря им, повышается эффективность работы лаборатории и клинические микроскопические исследования переводятся на современные стандарты.
Vision Basic
|
Vision Assist
|
Vision Pro
|
Vision Ultimate
|
Аппликационный модуль
|
Аппликационный модуль
|
Аппликационный модуль
|
Аппликационный модуль
|
Дополнительные модули
|
Дополнительные модули
|
Дополнительные модули
|
Дополнительные модули
|
Режим работы:
|
Режим работы:
|
Режим работы:
|
Режим работы:
|
Ручное сканирование |
Автоматическое сканирование |
Автоматическое сканирование |
Автоматическое сканирование |
1 слайд |
1 или 4 слайда |
4 или 8 слайдов |
До 200 слайдов |
Ручная подача |
Ручная подача через замену слайда /слайдов |
2 кассеты для слайдов |
Автоматическая загрузка слайдов |
Микроскоп |
Сканирующий микроскоп |
Сканирующий микроскоп |
Сканирующий микроскоп |
Персональный компьютер |
Персональный компьютер |
Персональный компьютер |
Персональный компьютер |
Монитор |
Монитор |
Монитор |
Монитор |
— |
— |
— |
Управляющий тач-монитор |
— |
— |
Встроенный считыватель штрих-кодов (опционально) |
Встроенный считыватель штрих-кодов |
— |
— |
Податчик иммерсионного масла (опционально) |
Податчик иммерсионного масла |
Объективы:
|
Объективы:
|
Объективы:
|
Объективы:
|
Светлое поле |
Светлое поле |
Светлое поле |
Светлое поле |
Освещение по Келлеру, LED |
Освещение по Келлеру, LED |
Освещение по Келлеру, LED |
Освещение по Келлеру, LED |
Двунаправленное подключение к ЛИС, LIS2-A2 (ASTM), HL7 |
Двунаправленное подключение к ЛИС, LIS2-A2 (ASTM), HL7 |
Двунаправленное подключение к ЛИС, LIS2-A2 (ASTM), HL7 |
Двунаправленное подключение к ЛИС, LIS2-A2 (ASTM), HL7 |